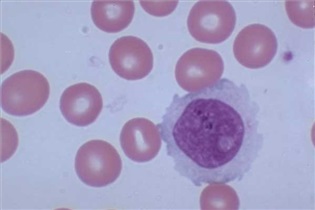

عفونتهایی که در بارداری خطرناک هستند
1-سرخجه: نوزادان متولد شده از مادرانی که در ماههای ابتدایی بارداری مبتلا به سرخجه میگردند میتوانند به اختلالاتی مانند کاتارکت(آب مروارید) ، میکروفتالمی ( کوچکی چشم ) ، ناشنوایی ، نواقص قلبی – عروقی و عقب افتادگی ذهنی مبتلا گردند. لذا مادر لازمست قبل از بارداری نسبت به این عفونت واکسینه شود.
2-توکسوپلاسما: ابتلای مادر به انگل توکسوپلاسما در دوره بارداری میتواند به عقب ماندگی ذهنی ، ناشنوایی و سقط جنین منجر شود.این انگل از طریق تماس با گربه یا خوردن سبزیجات آلوده به انگل به انسان منتقل میگردد.لذا لازم است مادران قبل از اقدام به بارداری از طریق انجام آزمایش خون نسبت به عدم ابتلا به این عفونت اطمینان حاصل نمایند و در زمان بارداری از تماس با گربه یا مصرف سبزیجات آلوده یا شسته نشده اجتناب نمایند.
3-سیتومگالوویروس: ابتلای مادر در سه ماهه دوم بارداری میتواند منجر به بروز میکروسفالی (کوچکی سر) ، میکروفتالمی (کوچکی چشم) و هیدروسفالی (آب آوردن مغز) گردد.لذا به مادران توصیه میشودقبل از بارداری از طریق آزمایش خون نسبت به عدم ابتلا به این ویروس اطمینان حاصل نمایند.
4-سیفیلیس : ابتلا به سیفیلیس در دوره بارداری میتواند ناشنوایی ، عقب ماندگی ذهنی و عیوب استخوانی در جنین ایجاد کند.
5-آنفلوآنزا : ابتلا به آنفلوآنزا در سه ماهه اول بارداری میتواند به عوارضی مانند عقب ماندگی ذهنی در جنین منجر گردد.
منبع: سایت محققین